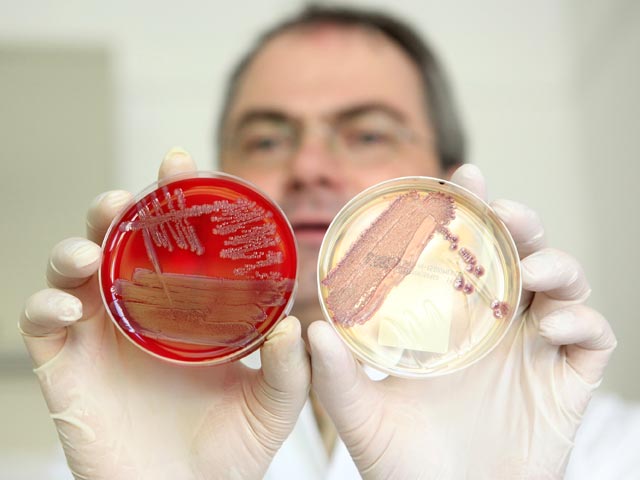

Реакция России на "супертоксичную бактерию" может вызвать массовую панику
Запрет российских властей на овощи из Европы - признак того, что вспышка кишечной инфекции на континенте рискует вызвать массовую панику. Причем произойдет это не только и не столько из-за самой эпидемии, сколько из-за ее последствий для сельского хозяйства и потребителей, констатируют наблюдатели.
Глава Минсельхоза Елена Скрынник поспешила заверить, что внутренние потребности России в овощах будут полностью удовлетворены, но независимые эксперты считают, что повышения цен не избежать. Есть и такая опасность - недобросовестные торговцы могут переложить товар из одной коробки в другую, с незапрещенной маркировкой. Такую опасную пересортицу может запросто устроить мелкий бизнес - на рынках, в небольших магазинчиках.
Наконец, если Россия будет жестко соблюдать эмбарго на ввоз овощей, европейские фермеры окажутся в еще более тяжелом положении, чем сейчас, лишившись одного из крупнейших рынков сбыта. Возможное развитие событий представляют в пятницу российские и зарубежные газеты.
- Цены уже пошли в рост. Покупателей предупреждают о возможном обмане на рынках
- Онищенко заподозрил власти ЕС в обмане
- Ученые: кишечную эпидемию вызвала токсичная бактерия-мутант
Как замечает "Коммерсант", наступление на овощном фронте сопровождается неразберихой: в тексте предписания управления Роспотребнадзора по Московской области, копия которого имеется у редакции, говорится, что изъятию подлежат "свежие овощи, съедобные корнеплоды и клубнеплоды" из стран ЕС. Однако в комментариях изданию главный санитарный врач РФ Геннадий Онищенко обмолвился, что картофель под запрет не подпадает.
Путь в Россию закрыт прежде всего огурцам, помидорам и салату из ЕС, а к указанным в документе другим "овощам и корнеплодам" относятся, видимо, капуста и морковь, сообщает "Московский комсомолец".
При этом эксперты говорят, что "изгнанники" со временем могут быть заменены продукцией из Турции, стран СНГ и Латинской Америки, и за огурцы и картошку как раз можно особенно не опасаться. А вот с разными видами салатов, томатами на ветке, а также черри, капустой и морковью могут возникнуть проблемы.
Не следует забывать, что отдельные виды овощей поставляются только или в основном из Европы - к примеру, цветная капуста, болгарский перец и помидоры черри. К потенциально дефицитным специалисты также относят брокколи и цукини.
"Новые известия" цитируют независимого эксперта, руководителя проекта "АПК-Информ" Андрея Ярмака: "За последний засушливый год Россия существенно нарастила импорт из ЕС, сейчас почти половина овощей на наших прилавках оттуда. Летом обычно импорт снижается до 7-10%. Правда, ранняя российская продукция начинает поступать не раньше конца июня. До этого при полном запрете всех овощей из ЕС и картофеля из Египта вполне возможно, что цены на лук, морковь и картофель, а также раннюю капусту будут выше обычного".
А управляющий партнер Management Development Group (сеть магазинов "Гастрономчикъ" и ресторанов "Ресторанчикъ") Дмитрий Потапенко предупредил в газете "Коммерсант", что ежемесячный рост цен на овощи летом может составлять 15-20%. Глава Федеральной антимонопольной службы Игорь Артемьев накануне заявил, что ведомство будет следить за ценами на овощи в связи с запретом импорта, так же не исключив, что из-за сокращения поставок у некоторых продавцов может возникнуть соблазн поднять цены.
Запрет чреват и потерей качества, говорят эксперты. "Огурцы из той же Турции едут к нам минимум две недели. Хотя нормальный огурец должен быть съеден в течение трех-пяти дней после того, как его сорвали", - привела пример МК представитель ассоциации "Теплицы России" Наталья Рогова.
Цены уже пошли в рост. Покупателей предупреждают о возможном обмане на рынках
В то же время "Российская газета" констатирует, что цены на овощи уже подскочили. Потребители отмечают, что огурцы и помидоры уже подорожали на 5-7 рублей, хотя объективных оснований для этого нет. По мнению производителей, причину того, почему эти овощи стоят в магазинах 80, 90 и даже 120 рублей, следует искать в диких и не контролируемых никем спекуляциях на рынке.
Издание также попыталось понять саму процедуру эмбарго. По мнению председателя правления Международной конфедерации обществ потребителей Дмитрия Янина, в России практика изъятия опасных продуктов из торговли отработана хорошо. Но в данном случае речь идет об очень большом объеме товара, поэтому потребуется две-три недели.
При этом не исключено, что недобросовестные представители мелкого бизнеса станут обманывать покупателей, поскольку распознать по внешнему виду, где выращен огурец или помидор, невозможно. По словам Янина, сейчас по всему миру используются одинаковые технологии промышленного выращивания, поэтому отличить можно только овощи, выращенные на даче. Выход для тех, кто опасается обмана - покупать овощи в магазинах крупной розницы, где вряд ли пойдут на подлог. Самые примечательные выдержки из российских СМИ по теме - на сайте "Заголовки.ру".
Для Европы принятые российскими властями меры стали весьма болезненными, поэтому неудивительно, что руководство ЕС жестко раскритиковало их, назвав "непропорциональными". В письме в Москву, которое цитирует The Financial Times, глава Еврокомиссии по здравоохранению и защите потребителей Паола Тестори Коджи заявила: "Я считаю такие меры диспропорциональными, не обоснованными научно и, следовательно, не соответствующими принципам (международных) соглашений (о торговле)".
Как указывается в статье, Россия - крупнейший рынок экспорта для европейских производителей овощей, крупнейшие поставщики - Польша и Голландия. Вспышка инфекции все более сказывается на политической жизни Европы и ее экономических связях, продолжает тему The New York Times. Если Россия будет жестко соблюдать эмбарго, европейские фермеры окажутся в еще более тяжелом положении, лишившись одного из крупнейших рынков сбыта, пишет издание, на которое ссылается InoPressa.
Онищенко заподозрил власти ЕС в обмане
Но российские власти не унимаются. Глава Роспотребнадзора Геннадий Онищенков в интервью Reuters подверг резкой критике власти Евросоюза за замалчивание причин и масштабов происшествия и заявил, что ситуация с распространением кишечной инфекции в Европе "вышла из-под контроля".
По его выражению, в течение месяца на территории Европы происходит то, что "встретишь не в каждой африканской стране". Главный санитарный врач России заподозрил власти ЕС в обмане: по его мнению, непонятно, почему источником заражения считаются испанские огурцы, если заболевание регистрируется в Германии, а в самой Испании "никаких заболеваний нет".
Заключив, что ситуация в Европе - "трагедия", порожденная непрофессионализмом, Онищенко пояснил, что решение о запрете на ввоз овощей из Евросоюза может быть пересмотрено лишь в том случае, если власти ЕС и Германии объяснят, "что у них происходит", передает РБК.
Ученые: кишечную эпидемию вызвала токсичная бактерия-мутант
Напомним, власти Германии забили тревогу в связи с распространением смертельно опасной кишечной инфекции в конце мая, когда умерли 10 человек и более 300 были признаны зараженными. К настоящему времени число заразившихся в Европе превысило 2 тысячи, жертвами стали 17 человек - 16 скончались в Германии и один в Швеции.
Как считали врачи, заболевание вызывает энтерогеморрагическая кишечная палочка - опасный штамм этой известной бактерии, способный вызвать тяжелые болезни и даже привести к смерти. Обычно она поражает пищеварительный тракт животных. У человека болезнь протекает в форме гемолитико-уремического синдрома, который характеризуется геморрагической диареей, острой почечной недостаточностью и анемией.
Но Всемирная организация здравоохранения в четверг заявила, что штамм, о котором идет речь, является принципиально новым микроорганизмом, с которым медицина ранее не сталкивалась.
Как там пояснили, это мутировавшая форма двух различных бактерий кишечной палочки, и именно этим объясняется столь стремительное распространение инфекции среди жителей европейских стран, а также ее опасность для жизни человека.
Ученые из университетской клиники Гамбурга совместно с китайскими коллегами расшифровали геном этого штамма бактерии и пояснили, что она представляет собой многоклеточный организм, совмещающий в себе свойства двух возбудителей болезни. На 80% она состоит из привычного штамма кишечной палочки и на 20% - из штамма более опасной и токсичной бактерии.